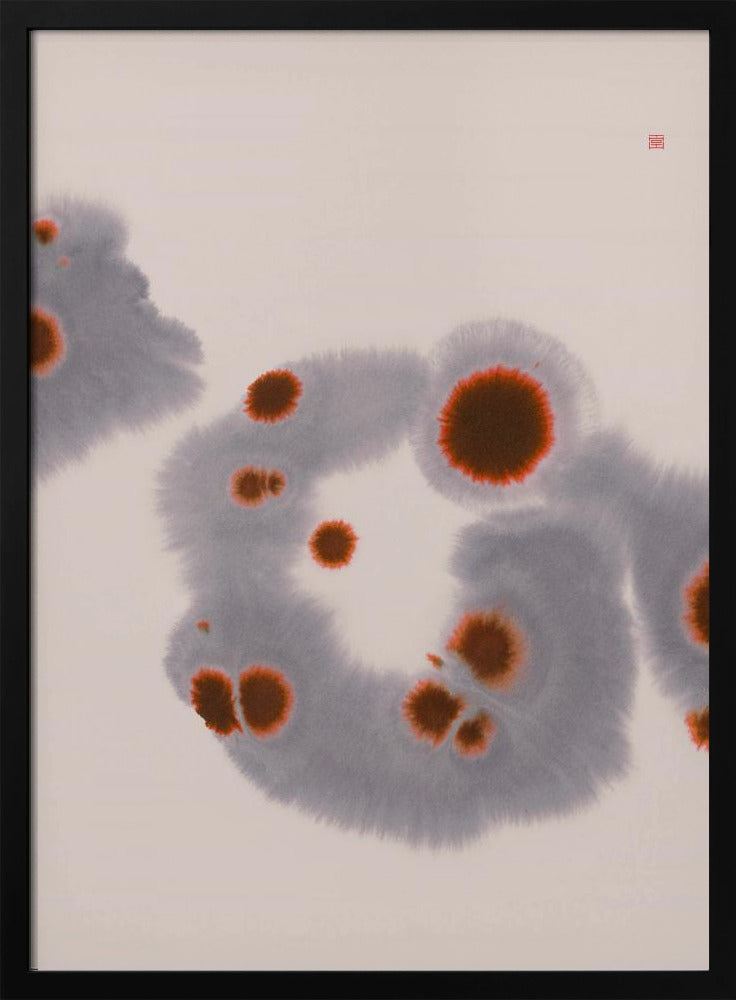

1
/
of
5
More from this artist: Thoth Adan
Floating | Poster
Floating | Poster
SKU:2737329-5
Regular price
€23,00 EUR
Regular price
Sale price
€23,00 EUR
Unit price
/
per
Taxes included.
Shipping calculated at checkout.
Product Highlights
- Framed art print with a printed matboard, offering high stability thanks to extra-strong cardboard (250 g/m²)
- Silk-matte texture gives the motif depth and underscores its character
- Ready to hang immediately – fully framed, sturdily mounted and immediately usable as wall decoration
- Housed in a solid floating-change frame – you can swap out the motif at any time
- Thanks to its neutral, high-quality framing, it suits any décor style – from modern to classic
Couldn't load pickup availability
Would you like a custom size for this?